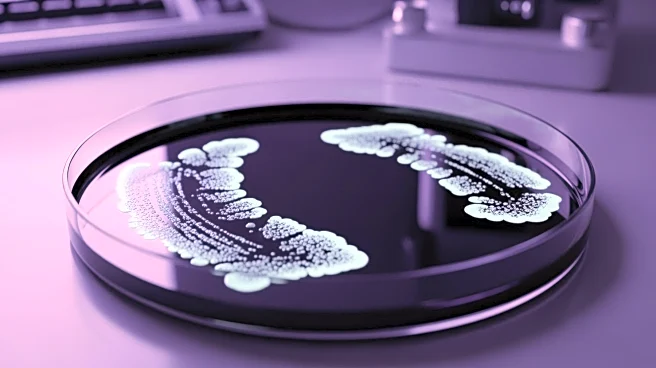
Researchers Develop Bacterial Strain to Enhance Chemotherapy Drug Production

What's Happening?
Meta has introduced four custom in-house chips designed for artificial intelligence tasks as part of its data center expansion strategy. These chips, part of the Meta Training and Inference Accelerator (MTIA) family, aim to improve performance and reduce
reliance on external vendors. The MTIA 300 chip was recently deployed, with the MTIA 400, MTIA 450, and MTIA 500 set to follow. These chips are intended to support AI-related tasks such as content recommendation and generative AI applications. Meta's Vice President of Engineering, Yee Jiun Song, highlighted the importance of these chips in diversifying Meta's silicon supply and insulating the company from price fluctuations.
Why It's Important?
Meta's development of custom AI chips represents a significant step in the tech industry's trend towards in-house silicon solutions. By creating its own chips, Meta can optimize its data center operations, potentially leading to cost savings and enhanced performance. This move also reflects a broader industry shift as tech giants seek alternatives to traditional GPU suppliers like Nvidia and AMD, which face supply constraints. The introduction of these chips could influence the competitive landscape, prompting other companies to invest in similar technologies to maintain their market positions.
What's Next?
Meta plans to continue rolling out its custom chips, with the MTIA 400 expected to be deployed soon and the MTIA 450 and MTIA 500 following in 2027. The company is also expanding its data center infrastructure, with new facilities under construction in Louisiana, Ohio, and Indiana. As Meta's AI capabilities grow, the company may face challenges related to supply chain constraints, particularly concerning high-bandwidth memory. Meta's approach to securing its supply chain and managing these constraints will be crucial in maintaining its competitive edge in the AI space.